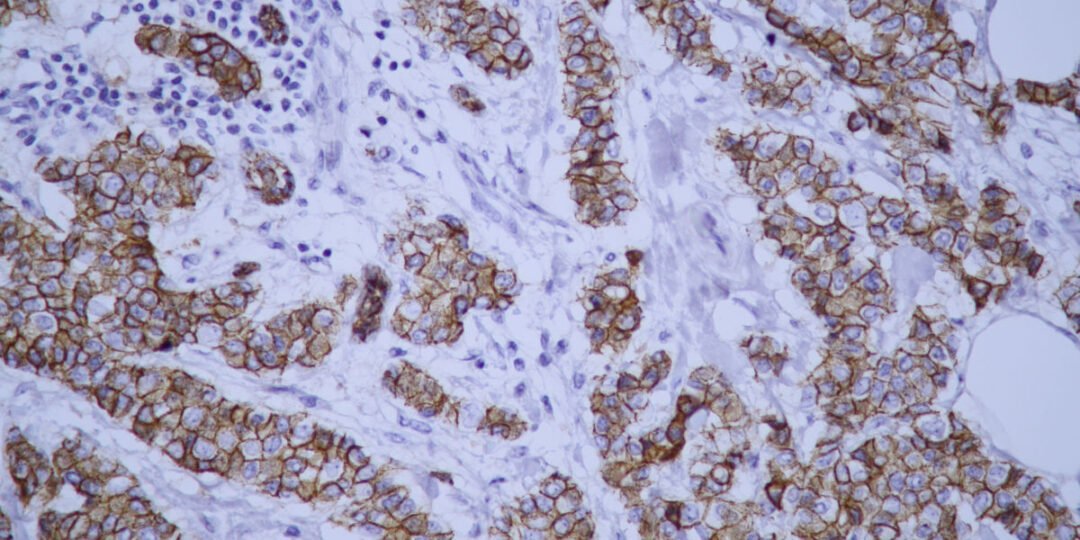

ODDELENIE PATOLÓGIE
ODDELENIE PATOLÓGIE

TELEFÓNNY KONTAKT

PRIMÁR
MUDr. Alexandra Budayová
alexandra.budayova@nspnz.sk
035 / 691 2302
Curriculum Vitae

VEDÚCI LABORANT
Mgr. Táňa Jobbágyová
tana.jobbagyova@nspnz.sk
035 / 691 2667
Curriculum Vitae
SEKRETARIÁT
 Je to technika farbenia histologických preparátov, ktorá umožňuje znázorniť prítomnosť v ideálnom prípade jednej konkrétnej látky pomocou špecifických protilátok. Využíva imunologickú väzbu antigénu s protilátkou. Ide o kombináciu dvoch vedných odborov a ich metodík, imunológie a histológie. Cieľom je dôkaz – vizualizácia prítomnosti či neprítomnosti určitých antigénov vo vyšetrovanom tkanive, priamo v tkanivových rezoch.
Je to technika farbenia histologických preparátov, ktorá umožňuje znázorniť prítomnosť v ideálnom prípade jednej konkrétnej látky pomocou špecifických protilátok. Využíva imunologickú väzbu antigénu s protilátkou. Ide o kombináciu dvoch vedných odborov a ich metodík, imunológie a histológie. Cieľom je dôkaz – vizualizácia prítomnosti či neprítomnosti určitých antigénov vo vyšetrovanom tkanive, priamo v tkanivových rezoch.
Obvykle sa používa tzv. nepriame imunohistochemické farbenie, pri ktorom sa v prvom kroku na tkanivový rez naviažu protilátky proti konkrétnym štruktúram. V druhom kroku sa používajú protilátky so značkou, ktoré sa viažu na protilátku z prvého kroku. V záverečnom kroku sa tkanivo inkubuje so substrátom, ktorý enzým premieňa na nerozpustný farebný produkt, a tak sa vlastne ozrejmí prítomnosť cieľovej štruktúry pri pozorovaní pod mikroskopom.
V posledných desaťročiach došlo k enormnému rozmachu využívania IHC vyšetrení. IHC sa stala súčasťou rutinnej bioptickej diagnostiky, využíva sa hlavne za účelom diagnostickým ale i prognostickým a prediktívnym.
Na úseku imunohistochémie sa ročne vyšetrí okolo 1400 prípadov a spracuje okolo 4700 preparátov.
Zoznam protilátok: Actin (Smooth muscle), Alfa-1-fetoprotein (polyclonal), AMACR (P 504-S), Caldesmon, Calretinin, Carcinoembryonic antigen (CEA monoclonal), Carcinoembryonic antigen (CEA polyclonal), CD10, CD30, CD31, CD34, CD45 (Leucocyte common antigen), CD56, CD99 (MIC2 Gene products; Ewing´s sarcoma marker), c-erbB-2, CD 117 (c-kit), CDX-2, Cytokeratin AE1/AE3, Cytokeratin 5/6, Cytokeratin 7, Cytokeratin 8, Cytokeratin 14, Cytokeratin 19, Cytokeratin 20, Cytokeratin-HMW, Dezmin, D2-40 (Podoplanin), E-cadherin, EMA, Estrogen receptor alfa, Gross cystic disease fluid protein-15 (GCDFP-15), Glial fibrilary acidic protein (G FAP), Hepatocyte, Helicobacter pylori, Chromogranin A, IDH-1, Inhibin alfa, Ki-67, Mammaglobin, Melan A, Melanosome (HMB-45), Napsin-A, Neurofilament protein (NF), Octamer-binding transcription factor 3/4 (OCT 3/4), PHH-1, Progesteron receptor, Placental alkaline phosphatase (PLAP), Prostate-Specific Antigen (PSA), p16, p40, p53, p120-Catenin, Renal cell carcinoma marker (RCC), Synaptophysin, S-100, Thyroglobin, Thyroid transcription factor (TTF-1), Vimentin…